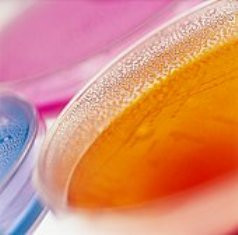

MICLAB-115
To define the procedures to be followed and the responsibility for the operation, calibration and maintenance of the Sievers 820 TOC Analyser with Autosampler.
MICLAB-115 TOC Analyser - Operation and Calibration of Sievers 820 (brand) Analyser